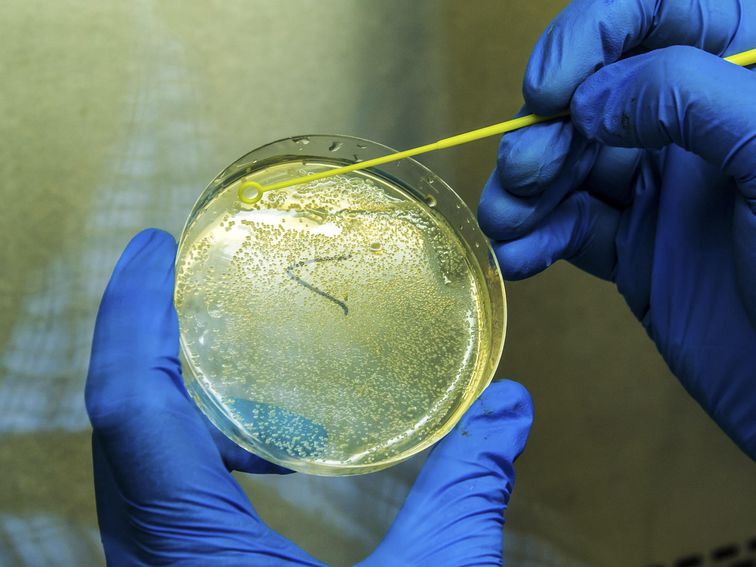

James Martin/CNET
For the most up-to-date news and information about the coronavirus pandemic, visit the WHO website.
Google has launched a new search tool that aims to make it easier for scientists and researchers to uncover information related to the coronavirus. The COVID-19 Research Explorer uses semantic search, a technique that employs artificial intelligence to surface meaningful results, to look through more than 50,000 journal articles and preprints in the COVID-19 Open Research Dataset.
In a blog post on Monday, Google research scientist Keith Hall wrote that…
Source CNET Tech
Source link